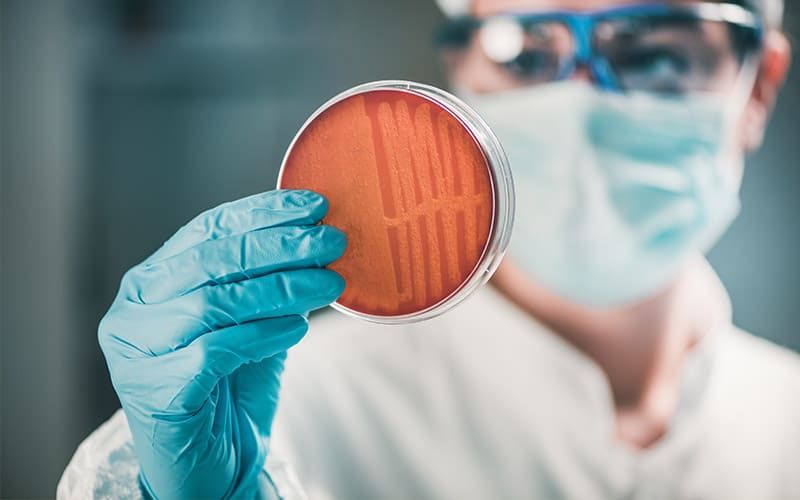

REMDESİVİRDEN DAHA FAZLA ETKİ GÖSTERDİ -
Çin'in Shenzhen Enstitüleri'nden Doktor Haiping Zhang liderliğindeki çalışma yazarları, “Covid-19'u tedavi edebilecek etkili ilaçların belirlenmesi, özellikle de klinik deneylerde hemen test edilebilen onaylanmış ilaçların tespit edilmesi önemli ve acildir.
Bilim insanları ilaçların taranmasının ardından laboratuvar deneylerinde yeni tip corona virüse karşı test edilen dört umut verici ilacı belirledi.
REMDESİVİR HAKKINDAKİ TARTIŞMALAR SÜRÜYOR -
Öte yandan çalışma, başlangıçta hepatit C'yi tedavi etmek için geliştirilen ve daha sonra potansiyel bir Ebola tedavisi olarak yeniden tasarlanan remdesivirin etkinliğine ilişkin bazı genel şüpheleri takip ediyor.
ABD’li ilaç üretici Gilead tarafından geliştirilen remdesivir bu yılki pandeminin ilk aşamalarında test edildi.
Araştırmacılara göre, pralatreksatın yan etkilerini ortadan kaldıracak şekilde yeniden kullanılması büyük potansiyel gösteriyor.
RdRP, yeni tip corona virüs de dahil olmak üzere i tüm RNA içeren virüslerin genomlarında kodlanmış temel bir proteine deniliyor.
İngiltere’de Ulusal Sağlık Enstitüsü (NHS), remdesiviri yardımcı olabileceği umuduyla Covid-19 hastalarında kullanım için onayladı.
Bu durum, ilacın potansiyel olarak Covid için yeniden tasarlanabileceğini düşündürdü.
Çalışmamız, pralatreksatın aynı deneysel koşullar içinde remdesivirden daha güçlü bir şekilde, yeni tip corona virüsün replikasyonunu güçlü bir şekilde inhibe edebildiğini keşfetti” ifadelerini kullandı.
Ancak, Çinli bilim insanları, pralatreksatın, şu anda Covid-19 hastalarını tedavi etmek için kullanılan remdesivirden daha iyi performans gösterdiğini keşfetti.
Kasım ayında ise Dünya Sağlık Örgütü (DSÖ) doktorların corona virüs hastalarını “ne kadar hasta olurlarsa olsunlar”' remdesivir ile tedavi etmemeleri gerektiğini ve ilacın işe yaradığına dair bir kanıtın olmadığını açıkladı.
İlaçlardan ikisi, pralatreksat ve azitromisin, virüsün replikasyonunu başarıyla yavaşlattı. Diğer laboratuar deneyleri ise pralatreksatın, viral replikasyonu remdesivir'den daha güçlü bir şekilde inhibe ettiğini gösterdi.
Çin’de yapılan yeni bir araştırmaya göre kanseri tedavi etmek için on yıldan uzun süredir kullanılan bir ilaç Covid-19 hastalarını iyileştirebilir.
Mevcut ilaçların sanal olarak taranmasına yardımcı olmak için Zhang ve meslektaşları, ilaç-virüs etkileşimlerini simüle eden çok sayıda hesaplama tekniğini birleştirdi.
Ancak, Aralık ayında, Nature Communications'da yayımlanan bir çalışmada, remdesivirin “bazı hastalar için” oldukça etkili bir Covid-19 tedavisi olabileceğini bildirdi.
Bununla birlikte, söz konusu ilaç toksisitesine rağmen ölümcül kanseri olan hastalar için 2009 yılında ABD Gıda ve İlaç Dairesi tarafından onaylandı. Pralatreksatın yan etkileri arasında ise yorgunluk, mide bulantısı ve mukozit bulunuyor.
BİN 906 İLACIN COVİD-19'A KARŞI POTANSİYELİ İNCELENDİ -
Yapılan çalışma kapsamında araştırmacılar, başlangıçta diğer koşulları tedavi etmek için geliştirilen mevcut ilaçları yeniden kullanma fikrinden ilham alarak yapay zekadan yararlandı.
RNA'ya bağımlı RNA polimeraz (RdRP) adı verilen bir viral proteini hedefleyen ve yeni tip corona virüsün çoğalmasını azaltma potansiyeli olan bin 906 mevcut ilacı yapay zeka ile tarandı.
Pralatreksat adı verilen ilaç, lenf bezlerinden kaynaklanan tümörleri (lenfoma) tedavi etmek için kemoterapide kullanılmak için geliştirdi.
İlacı XLA adı verilen ve enfeksiyonla savaşmak için antikorlar üretmesini engelleyen genetik bir bozukluk nedeniyle Covid-19’la savaşmayan 31 yaşındaki bir hastanın iyileşmesine yardımcı oldu.